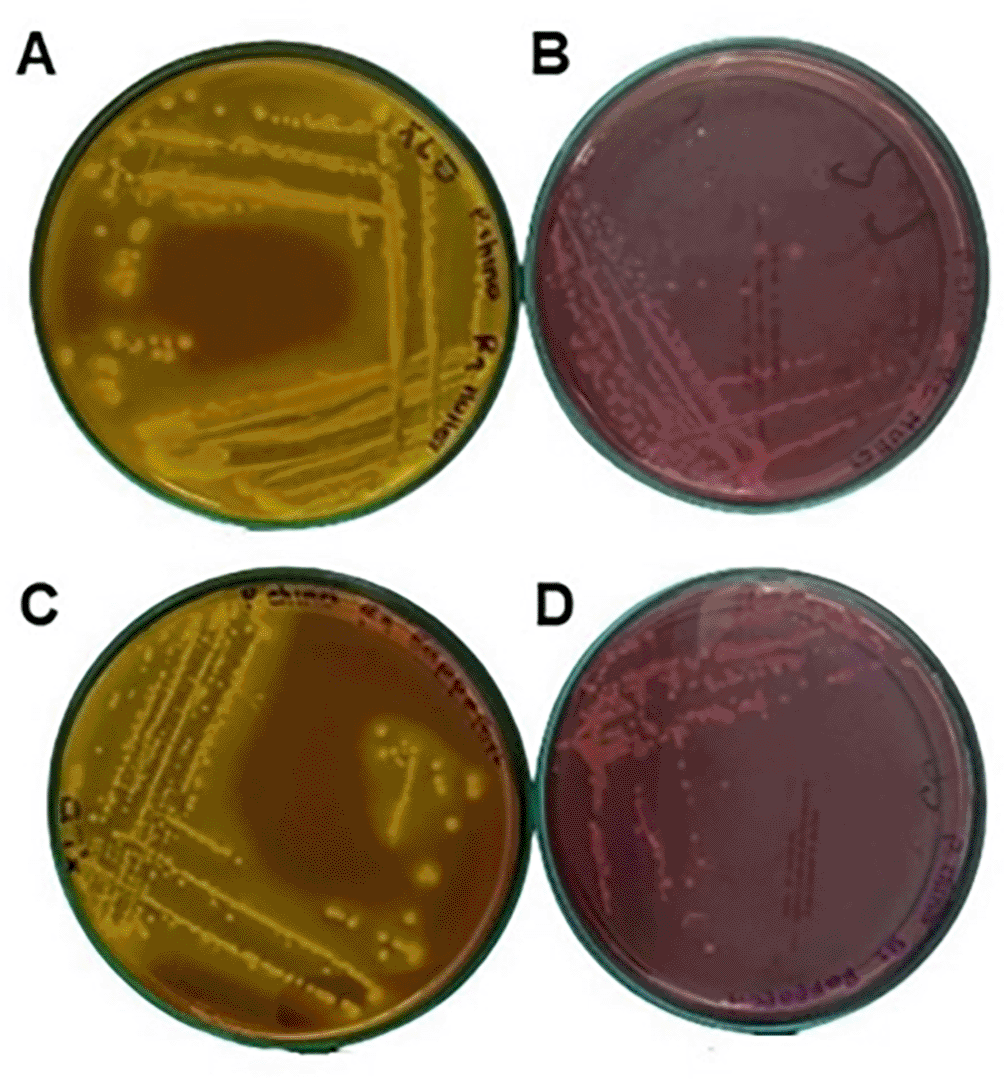

Keywords
Rheology properties, Proximal composition, Microbiological quality, Gluten-free foods
Rheology properties, Proximal composition, Microbiological quality, Gluten-free foods
In the new version, the figure of the sacha inchi defatting process is added.
Units are verified and adjusted, paragraph 1 of the introduction is rewritten. All the comments requested by the reviewer are adjusted.
See the authors' detailed response to the review by Lorena Sciarini
See the authors' detailed response to the review by Elisa Julianti
See the authors' detailed response to the review by Umi Purwandari
See the authors' detailed response to the review by Diego Salazar
See the authors' detailed response to the review by Oluwaseun P Bamidele
According to Ref. 1, by 2050, if governance allows for debate and equity in global food and if food demand is very high, driven by rapid population growth, a high intensity of land use will be required to meet the demand for food, mainly meat and dairy products that are important sources of protein, vitamins and minerals in the human diet.2 However, intensive livestock production is unsustainable from an environmental point of view, due to the demand for resources such as land to produce the crops needed for animal feed and fresh water; in addition, animal production is associated with the generation of greenhouse gases, a situation that contributes to the acceleration of global warming.3 Therefore, it is possible to achieve an adequate protein intake through the right combination of proteins of vegetable origin.
In this scenario, we must design food systems to contribute to global environmental sustainability and meet nutritional needs, proposing diets based on plants that allow including adjustments according to each region coupled with cultural customs.4 Underutilized or orphan crops are used to design original foods, not aimed at international trade, however, because of their high adaptation to the local environment, these crops play an important role in regional nutritional security.5 The mixture of plants such as cereals, pseudocereals, legumes, tubers, among others, are used to create different products with adequate balance of protein, carbohydrates, fiber and micronutrients such as vitamins and minerals.
For example, sacha inchi (Plukenetia volubilis) known as wild peanut, Inca peanut, sacha peanut or mountain peanut, is an oleaginous plant that belongs to the Euphorbiaceae family.6 Today, sacha inchi is still cultivated in the lowlands of the Peruvian Amazon and has been planted for centuries by the indigenous population.7 In Colombia, according to Ref. 8, production exceeds 2,400 tons of sacha inchi seed. The department of Putumayo is the largest producer of sacha inchi with 282 hectares, followed by Valle del Cauca, Caquetá and Antioquia.
Sacha inchi is a promising and industrializable food native to the Amazon that has essential unsaturated fatty acids such as omega-3, as alpha-linoleic acid with 47.7% to 51.9% and omega-9 as oleic acid with 7.9 to 8.9% by weight of oil, 27.4% protein, 4% ash and about 50% oil.9 These nutritional properties make sacha a favorable food for health and a suitable crop for developing high-protein and gluten-free foods.
Taro is a tuber abundant in starch of which 17-28% is amylose and the remaining is amylopectin.10 Taro has a high content of resistant starch that allows slow digestion with valuable effects on cholesterol and blood glucose regulation.11 Taro has a high carbohydrate (59.36%) and protein (24.99%) content, with respect to the mineral content of taro, the highest amount present is magnesium 242.373 mg/kg, followed by calcium 94.455 mg/kg, iron 8.351 mg/kg and zinc 6.210 mg/kg, and, in relation to vitamins, is reported content of vitamin C 0.188 mg/100 mg, vitamin B1 0.047 mg/100 mg, and vitamin B3 0.078 mg/100 mg.12 Compared to other tubers such as sweet potato, potato, cassava and yam; taro has a higher protein and fat content.12 Likewise, taro has flavonoids and phenolic acids that have antioxidant properties; flavonoids, the largest group of phenolic compounds identified in the whole plant, are associated with reducing many degenerative diseases.11
Foodstuffs are complex systems of great nutritional richness and therefore sensitive to attack by microorganisms (bacteria, fungi and yeasts). The main mode of contamination of raw materials is animal defecation, manure fertilization and recontamination persisting in facilities and transport; in addition, insects and rodents are a source of contamination.13 The low water activity (aw<0.60) of meal does not favor microbial growth; however, contaminating spores along with inactive microorganisms will remain viable for prolonged periods and constitute a potential health hazard. As a persistence mechanism, Salmonella and other pathogens form biofilms that protect against disinfection and increase their tolerance to drying processes.13
In food matrices there is always a microbial load that must not exceed certain limits, according to Colombian regulations, which must be controlled to avoid the deterioration of the product and the consequent loss of its quality and suitability for consumption.
The design and production of new foods that respond to food and nutritional security in the midst of climate change in low-income countries is a challenge, so this study aimed to characterize the chemical, microbiological, rheological and bioactive properties of individual flours and mixtures of taro and sacha inchi, as potential foods applied in the formulation of different foods.
The taro tubers were bought in the Municipality of Orito Putumayo, located at 0° 38′ North Latitude and 76° 37′ West Latitude of Greenwich. Average temperature of 25 °C and relative humidity of 88%. The fresh Sacha inchi almonds were supplied by the company Fruty Amazónicos S.A.S. located in the village of La Concordia in the municipality of Valle del Guamuez, located at 00° 25″ north latitude and 76° 54″ west longitude. Temperatures range between 27 °C and 40 °C.
The taro flour (TF) was obtained following the methodology of Ref. 10. The raw material was received, the peel was removed; it was washed to eliminate impurities and then the edible part was cut into slices to facilitate dehydration; then it was weighed on a FENIX Electronic Weight Only Table Scale to verify yield, subsequently it was dried in a rotary oven (ORVES, Colombia) at a temperature of 60 °C for five hours to eliminate excess moisture. The dried slices were then ground in an electric mill (Quaker City Mill, model 4-e, Philadelphia) and then passed through a 30-mesh sieve system to achieve homogeneity in flour particle size.
Sacha inchi seeds were received in white kernel, i.e., without shell or husk. The flour was obtained using the two methods described below:
Wet method
Sacha inchi flour from the wet method (SIF-WM), was obtained as follows: wet milling was performed in a blender (Oster, BLST 4655, Colombia) of 1.25 L, to which the sacha inchi and water were added in a 1:3 ratio, this, in order to disintegrate the grain. Obtaining a milky and homogeneous suspension. In order to separate the insoluble extract (cake) from the water-soluble extract (milk), a cloth filter was used and then the cake was dried in an oven at a temperature of 65 °C for 3 hours. Once dehydrated, it was immediately packed in a hermetically sealed polyethylene bag.14
Defatted method
The defatted sacha inchi (SIF-DM) flour was obtained as follows: the sacha inchi kernel was placed in the hopper of the automatic tactile oil extraction press (CGLDENWALL, store model K28, Shanghai China), as shown in Figure 1, a temperature of 124 °C was used. The press used the screw, which pushed the material into the main pressing cylinder, the pitch of the screw and the depth of the spiral were reduced, decreasing the volume available in the chamber, and the material being subjected to high pressure accompanied by friction against the closed bottom wall of the cylinder produced the extraction of the oil. The oil then flows through the existing orifices in the cylinder. The remaining material exits through the pressing system and the cake outlet nozzle.
The proximate composition (protein, lipids, dietary fiber, ash and moisture) of taro and sacha inchi flours was determined according to the methods proposed by the AOAC (Association of Official Analytical Chemists, 1990)15 and the carbohydrate content was estimated by difference. The details of the method are explained in more detail in the protocols uploaded in the repository.
Water activity measurement
To determine the aw of the raw materials, the powdered sample was placed in a Decagon Pawkit portable water activity meter until the cuvette was covered. Before reporting the measurement, the equipment was calibrated with standard salts at 0.25 (13.41 mol/Kg LiCl 0.25 aw) and 0.76 (6.00 mol/Kg NaCl 0.76 aw).
Protein
On nitrogen-free paper, 0.2 to 0.8 g of sample plus 1 g of kjeldahl catalyst were weighed and placed in digestion tubes. 10 mL of sulfuric acid were added. Then, gentle heating was initiated until no foaming or splashing was observed, using a temperature ramp as follows: 125 °C for 30 min, 270 °C for 30 min and 400 °C for 140 min.
The samples were digested until they were completely clear and translucent, free of organic matter, in the laboratory Kjeldahl digester (Raypa MBC-6/N, Spain).
Then they were cooled to room temperature in the Raypa distillation unit, after which each sample was titrated with 0.1 N HCl.
Lipids
For lipid testing, 1 g of sample was weighed in the extraction cartridges, then 80 mL of petroleum ether was added, immediately transferred in the rack to the laboratory Soxhlet and Randall Extractor (SX-6MP, RAYPA, Spain). After the extraction time and solvent recovery, the samples were placed in an oven at 60 °C for 1 hour to eliminate the remaining ether.
Fiber
For fiber testing, 1-2 g of the degreased sample were transferred to the laboratory fiber extractor (F-6P Fibertest, Spain) and fixed to the angle of the front part of the unit. Then 150 mL of 0.255 N H2SO4 was heated in an Erlenmeyer flask, when it was boiling, it was placed on top of the coolant, the heating knob was adjusted to boiling point 3 or 4 and left boiling for 30 minutes. At the end of this time, it was filtered and washed with distilled water and the operation was repeated 3 times using 30 mL of water each time. Then, 150 mL of sodium hydroxide solution preheated to 90 °C was placed in the upper part of the cooler; it was brought to boiling and kept for another 30 minutes. Then it was filtered and washed three times with boiling water. The sample was then placed in an oven at a temperature of 100-110 °C until a constant weight was obtained.
The determination of polyphenols was performed according to Ref. 16, with slight modifications. Two grams of the sample were weighed in a 50 mL falcon tube. The first fraction was added to the sample 8 mL of solution with 80% ethanol and 20% water and 1% formic acid (80 mL ethanol + 20 mL water + 1 mL formic acid). The samples were shaken for 25 minutes in a shaker at 200 RPM at room temperature. The samples were then centrifuged at 3500 rpm for 5 minutes at room temperature. Subsequently, the supernatant was taken in a new falcon tube (50 mL) and then 40 microliters of EDTA 2% was added to the supernatant.
For the second extraction, 8 mL of 70% acetone with 1% formic acid (70 mL acetone + 30 mL water + 1 mL formic acid) was added to the pellet of the first extraction. The pellet was shaken in solution for 25 minutes in the shaker at 200 RPM at room temperature. Subsequently, the samples were centrifuged at 3500 rpm for 5 minutes at room temperature and the second supernatant was poured into the first supernatant and mixed. Finally, the supernatant mixture was made up to 20 mL using distilled water and the absorbance was measured in the spectrophotometer (Thermo scientific, Genesys 10S UV VIS).
In a test tube 4 mL of ABTS.* (2,2′-Azino-bis(3-ethylbenzthiazoline-6-sulfonic acid), solution was added and to start the reaction 135 μL standard solution and vortexed for 5 seconds. A reagent blank was carried with 4 mL of 4.5 acetate buffer and 135 μL of ethanol, point 0 was prepared by adding 4 mL of ABTS solution and 135 μL of ethanol. Finally, the tube was capped and waited exactly 30 minutes to measure the absorbance in the spectrophotometer (Thermo scientific, Genesys 10S UV VIS) at a wavelength of 729 nm.
Pasting properties
The pasting properties of each dispersion were determined using a rheometer (TA INSTRUMENTS, AR 1500, New Castel, USA), equipped with a starch pasting cell. Then, a suspension of flour in water with a concentration of 12% (w/w) in 25 g was prepared and exposed to heating and cooling. The following samples were analyzed: 100%TF; 100%SIF-DM; 100%SIF-WM; 25%SIF-DM:75%TF; 50%SIF-DM:50%TF; 75%SIF-DM:25%TF; 25%SIF-WM:75%TF, 50%SIF-WM:50%TF; 75%SIF-WM:25%TF. The shear rate was kept constant at 16.75 s-1, throughout the heating and cooling range (25 °C–90 °C–25 °C) while the heating rate was 10 °C/min. The following parameters were obtained from the rheological analysis maximum viscosity [Pa.s]; minimum viscosity [Pa.s]; breakthrough viscosity [°C] and setback viscosity [Pa.s]. Finally, using the Savistky-Golay function, the data were smoothed in the GraphPad Prism 8.0.1 program (RRID:SCR_002798).17,18
Flow profile
Flow properties were performed according to the methodology of Ref. 17 with modifications. An AR1500 rheometer (TA Instruments, New Castel, USA) was used in this study. The average viscosity was determined at 25 °C for 12 min with a shear rate increasing in 4 steps as follows:
Step 1: 1×10-3 s-1 to 1×10-2 s-1
Step 2: 0.01 s-1 to 0.1 s-1
Step 3: 0,1 s-1 to 1 s-1
Step 4: 1 s-1 to 100 s-1
Subsequently, the sample was heated to 90 °C. Once this process was completed, the average viscosity was determined again at 25 °C, subjecting the sample to the same shear rate.
Flow curves (shear stress versus shear rate) were obtained and fitted to the power law model shown in Equation 1.
Where:
T is the shear stress (Pa).
y is the shear velocity (s-1)
K is the coefficient of consistency (Pa. s-1)
n is the flow behavior index
The flow behavior index indicates Newtonian flow behavior when n = 1, shear thinning behavior when n < 1 and shear thickening when n > 1). Consistency and creep were determined before and after heating in order to determine the effect of thermal processing on these parameters.
Determination of viscoelastic properties (temperature sweep)
For the determination of viscoelastic properties (temperature sweep) the method of Ref. 19 was used, the viscoelastic properties were determined in a rheometer (TA INSTRUMENTS, AR 1500, New Castel, USA) using a system of parallel flat plates, of 40 mm diameter and 1500 μm distance between plates. The edges of the plates were sealed with vaseline, with the purpose of controlling evaporation and avoiding variations in concentrations of the aqueous suspensions used.
The samples were subjected to a cycle of dynamic heating (25-85 °C), stabilization (85 °C for 2 minutes) and cooling (85-25 °C) at 10°C/min, with a frequency of 0.5 Hz and 0.5% deformation. The profiles of the viscoelastic moduli as a function of temperature were recorded using the equipment’s software.
The microbiological characterization of the flours was carried out, considering the methodology reported by Ref. 20, which was based on parameters established by the Colombian technical standard NTC that applies for each microorganism.
To perform the microbiological characterization, 10 g of sample were taken in triplicate, then diluted in 90 mL of peptonized water and mixed at 150 rpm for 10 min in a shaker (MaxQ 4450 orbital Thermo Ficher Scientific USA), following this, for each microorganism the seeding of the appropriate dilution and selective medium is described. The details of the method are explained in more detail in the protocols uploaded in the repository https://doi.org/10.5281/zenodo.7582202.
Coliforms
1 mL of each replicate was taken and seeded in a previously sterile Petri dish by seeding in depth on chromogenic colinstant agar for 24-48 h of incubation at 35 °C.
Mesophiles
1 mL of sample was taken from each replicate, and each dilution was seeded by immersion in previously sterile Petri dishes in Plate Count Agar (PCA) agar for 24-72 h at 30 °C.
Fungi and yeasts
100 μL of each replicate was taken and seeded per surface in previously sterile Petri dish by surface plate seeding on Potato Dextrose Agar (PDA) agar for 24-72 h incubation at 30°.
Bacillus cereus
100 μL of each replicate was taken and surface seeded in previously sterile Petri dish by surface plate seeding on Mannitol egg Yolk Polymyxin agar (MYP) agar with egg yolk specific for Bacillus cereus for 24 h incubation at 37 °C.
Staphylococcus aureus
100 μL were taken from each replicate and seeded per surface in a previously sterile Petri dish, by surface plate counting on Baird Parker agar at 24 h incubation at 35 °C, and then incubated for 24 h at 35 °C.
Salmonella
25 g of sample were taken in duplicate, then diluted in 225 mL of buffered pepton water and mixed at 150 rpm for 10 min in shaker (MaxQ 4450 orbital Thermo Ficher Scientific USA), once this time was over, they were left in incubation at 37 °C for 18 h, after which 100 μL were inoculated in 10 mL of Rappaport Vassiliadis malachite green broth (RVS medium) at 41. Furthermore, 1000 μL were inoculated in 10 mL of Tetrationate Mueller Kauffmann broth (MKTTn medium) at 37 °C for 24 h. After this time, the surface of a Petri dish containing XLD agar selective medium was seeded by means of a loop in such a way that asylated colonies were obtained, Salmonella Shiguella agar was incubated at 34 °C for 24 h, at the end of which typical colonies of Salmonella spp. were observed.
A completely randomized design (nine treatments) was used to evaluate the rheological properties of native and formulated flours. The design was based on the type of flour and its inclusion levels in the mix, which were: 100% TF; 100%SIF-DM; 100%SIF-WM; 25%SIF-DM:75%TF; 50%SIF-DM:50%TF; 75%SIF-DM:25%TF; 25%SIF-WM:75%TF; 50%SIF-WM:50%TF; 75%SIF-WM:25%TF. The response variables were viscosity as a function of temperature-shear rate and viscoelastic modulus (G′ and G″).
The results were presented as the mean ± standard deviation of triplicate experiments. One-way analysis of variance (ANOVA) was used to compare means. Differences between means were considered significant at P < 0.05 using Tukey’s new multiple range test. Data were subjected to analysis with Minitab version 20 (RRID:SCR_014483), https://www.minitab.com/es-mx/support/downloads/. Graphs were generated in Graphpad Prism 5.0.
Table 1 shows the results of the proximate analysis for the samples. Plukenetia volubilis seed on dry basis has a high lipid content (52.84%) like oilseeds such as soybean (16.61-24.71%), almond (Prunus dulcis) and peanut (Arachis hypogaea) whose values vary around 50%.21,22
The results of lipids are within the range of values reported by Refs. 23–26. The protein content of sacha inchi kernel (33.73%) is above the range, but close to the value reported by Ref. 24. As for ash, the value was 3.05%, crude fiber (3.71%), and carbohydrates (6.67%). Regarding moisture, sacha inchi seed presented a 6.62%, close to the value reported by Ref. 26 with 6.28%.
Two methods were used to obtain sacha inchi flour: the wet method and mechanical defatting.
Wet method: The flour obtained by the wet method had an oil content of 8.87% and a protein content of 31.54%, with a protein/fat ratio of 3.56. The high protein values obtained from sacha inchi cake using this mechanical pressing method are the basis for the formulation of protein-rich foods using vegetable sources.
Mechanical defatting method: the sacha inchi flour obtained by the mechanical defatting method had a protein content of 72.62%, being above the range of values reported by Refs. 23, 27–30 which vary between 41.49 and 65.6%.
Crude fiber has a value of 7.71%, the carbohydrate content is 3.04%, below that reported by Ref. 27 with a value of 11.25%. This difference can result from suspended solids carried in the oil stream.
The comparison of the two methods for obtaining sacha inchi flour (SIF-DM and SIF-WM) made it possible to see the method that presented the highest protein content was SIF-DM with 72.62% compared to a value of 31.55% for SIF-WM. The lipids results were close, 9.84% for the SIF-DM and 8.87% for SIF-WM. As for fiber, SIF-WM presented higher values (19.42%) compared to SIF-DM (7.71%).
Taro flour: as shown in Table 1, carbohydrates are the major component of taro with a value of 85.42%. The values of protein (6.05%), ash (5.18%), and lipids (0.70%) from proximate analysis agree with research.10,31–35 Crude fiber is the only data below the range consulted with a value of 2.65%, the closest value being that reported by Ref. 35 with a value of 4.38%.
Table 2 shows that the total polyphenols obtained in the flours are statistically different, taro flour presents the highest polyphenol content of 7.50 ± 1.73 mg GAE/g, being like those reported by Ref. 36, in comparison with flours from other sources such as plantain (5.93 ± 0.43 mg GAE/g)37 present a higher value. The defatted sacha inchi flour presented a polyphenol content of 3.37 ± 0.16 mg GAE/g flour, being higher than the flour obtained by the wet method, because the mechanical extraction involving pressure and temperature allows a release of phenolic compounds.38
| Raw material | FPP (mg GAE/g sample) | ABTS (μmol ET/g sample) | aw |
|---|---|---|---|
| TF | 7.47a ± 0.27 | 2.71a ± 0.02 | 0.61 |
| SIF-WM | 2.68c ± 0.26 | 0.49b ± 0.02 | 0.64 |
| SIF-DM | 3.37b ± 0.16 | 0.71c ± 0.04 | 0.54 |
Antioxidants present in foods play an important role in their preservation because they prevent oxidation processes; in addition, these compounds contribute to health promotion through the prevention of pathological processes mediated by oxidative stress. Therefore, the formulation of new foods that present bioactive compounds is attractive for the new trends in the design of new foods.
Regarding the antioxidant activity measured by the ABTS method, taro flour obtained a statistically higher antioxidant activity with 2.71 ± 0.02 μmol ET/g compared to SIF-DM (0.49 ± 0.02 μmol ET/ g) and SIF-WM (0.71 ± 0.04 μmol ET/g). This difference can be explained because taro is a prime source of antioxidant compounds and, from a chemical point of view, has various biologically active phytoconstituents, such as flavonoids, sterols, and glycosides.39
In this study, a TF drying temperature of 60 °C was used, which according to Ref. 40, temperatures between 50 °C and 60 °C allow for maximum antioxidant activities in taro flours. SIF-DM presented the lowest antioxidant activity, possibly due to the fact that during extraction the oil stream carries away bioactive compounds, which in sacha inchi are present particularly in polyunsaturated essential fatty acids, phytosterols and tocopherols, which are divided into three chemical categories: α-linolenic acid, β-sitosterol and γ- and δ-tocopherols.41
Pasting curves
The viscosity profile was carried out to know the evolution of viscosity during the heating and cooling phase in the raw materials and in each of the blends. According to the statistical analysis, the different flour blends significantly affect viscosity p < 0.05. Figure 2A shows the significant differences between the blends in the viscosity peak, according to the post hoc Tukey analysis five different groups identified with letters from “a” to “e” are classified. In group “a”, the samples with the highest viscosity (25%SIF-DM:75%TF and 100%TF) with values of 3.08 Pa.s and 2.99 Pa.s respectively, and in group “e”, the samples with the lowest viscosity value (75%SIF-WM:25%TF and 100%SIF-WM) with values of 0.35 Pa.s and 0.64 Pa.s respectively.

The data represent the significant differences in the values of: (A) viscosity peak [Pa.s]; (B) Trough [Pa.s]; (C) Breackdown [°C] and (D) setback [Pa.s]. The acronym (TF) refers to taro flour; (SIF-WM) sacha inchi flour by wet method and (SIF-DM) sacha inchi flour by defatted method.
According to the results, the samples with higher TF content present the highest viscosity peaks, due to the presence of starch contributed by TF, taking into account that in this study taro, presented 85.42% of carbohydrates that according to Ref. 42 are represented by starch. Starch granules are not soluble in cold water, because of the strong hydrogen bonds that hold the starch chains together. Starch heated in excess water and above the pasting temperature suffers an order-disorder phase transition called gelatinization. This transition is associated with water diffusion in the granule, water absorption by the amorphous region, hydration and radial swelling of the starch granules, leading to an increase in viscosity. As Figure 3 shows, the greater the presence of a starch source, the higher the viscosity peak. This positive correlation of starch content with peak viscosity is consistent with research on different commercial flours from cereals, pseudocereals, roots, and legumes.43 Comparing SIF-DM flour with SIF-WM, the defatting method produces a flour with higher viscosity, due to the interaction of water with proteins and starch,18 taking into account that SIF-DM has 72.62% protein. It can be attributed that the lower viscosity of the sacha inchi flour obtained by the wet method is due to the large particle size of the flour, due to its high oil content, which is shown in Table 2; it was not possible to perform a size reduction and we worked with the granules resulting from the liquefaction process and subsequent drying. Therefore, the endogenous lipids present in taro flour form a kind of protective layer of the carbohydrate and protein agglomerate, preventing water absorption and subsequent swelling of the starch.44

The graphs show the flow profile behavior of: (A) SIF-DM; (B) SIF-WM; (C) TF; (D) 25%SIF-DM:75%TF; (E) 25%SIF-WM:75%TF; (F) 50%SIF-DM:50%TF; (G) 50%SIF-WM:50%TF; (H) 75%SIF-DM:25%TF; (I) 75%SIF-WM:25%TF. The acronym (TF) refers to taro flour; (SIF-WM) sacha inchi flour by wet method and (SIF-DM) sacha inchi flour by defatted method.
Figure 2B shows the significant differences in the samples behavior before the onset of retrogradation (trough or drop viscosity), which occurs at the end of the constant temperature section, before cooling begins. There are six different groups, identified with letters from “a” to “f”, where in group “a”, are the samples with the highest trough value of 25% 25%SIF-DM:75%TF, with values of 1.84 Pa.s and 1.83 Pa.s respectively, and in group “f”, are the samples with the lowest trough value of 75%SIF-WM:25%TF and 100%SIF-WM with values of 0.1 and 0.02 respectively.
According to the above, as shown in Figure 3, the samples that presented a higher viscosity drop are the samples with higher TF content, this is because the crystalline structure (amylopectin) that makes up the granules is altered, when amylose and amylopectin are hydrated individually in excess water, both macromolecules tend to reorganize in a similar structure to the one they had initially.45
As shown in Figure 3, mixtures with higher inclusion of starch present in tf and less protein contributed by sacha inchi result in more free water for starch molecules to swell and solubilize presenting higher viscosity; on the contrary, at high proportions of protein its interaction with starch granules could stabilize the amylose leaching channel of starch granules, which resulted in lower swelling power and solubility.46
Figure 2C shows the significant differences in the samples behavior in the breakdown stage. According to Ref. 47, the breakdown or stability is the difference between the viscosity peak and the trough in the constant temperature section and shows disintegration at a maintenance temperature (95 °C) during continuous shear; the lower the Breackdown value, the higher the anti-shear capacity. In this study, according to the post hoc Tukey analysis six different groups identified with letters from “a” to “f”. In group “a”, the samples with the highest breakdown value (25%SIF-DM:75%TF and 100%TF) with values of 1.24 Pa.s and 1.16 Pa.s respectively, and in group “f”, the samples with the lowest value (100%SIF-WM) with values of 0.040 Pa.s. It was evidenced that the samples with low starch content contributed by taro present higher stability, while the samples with higher starch content have lower capacity to support viscosity during prolonged heating, because of the starch behavior, in which the low molecular weight amylose separates from the starch granule and they collapse at constant temperature until the amorphous part is solubilized, decreasing viscosity.48
Figure 2D shows the significant differences between the mixtures in the setback parameter, according to the post hoc Tukey analysis five different groups identified with letters from “a” to “e”. In group “a”, we find the samples with the highest setback (100%TF and 25%SIF-DM:75%TF and 100%TF) with values of 1.69 Pa.s and 1.60 Pa.s respectively, and in group “e”, the samples with the lowest values (75%SIF-WM:25%TF and 100%SIF-WM) with values of 0.13 Pa.s and 0.03 Pa.s respectively. The variable reorganization or setback is the indicator of the retrogradation and rearrangement of starch molecules during the cooling process that defines the reabsorption of soluble starch polymers and insoluble granular fragments during the cooling phase.49 According to the results, blends containing lower taro content are less prone to retrogradation. As mentioned above, starch (amylose-amylopectin) contributed by TF with variations in temperature generates changes, e.g., amylose forms double helix associations of 40 to 70 glucose units, since amylopectin crystallization occurs by reassociation of the outermost short branches, i.e., both amylose and amylopectin are capable of retrogradation, although the amylopectin seems to be responsible for long-term quality changes in foods.50 In taro starch, amylopectin contents are higher than amylose 66 and 34 % respectively,51 which is the reason for attributing higher retrogradation in flour blends with higher TF.
Flow profile analysis
Figure 4 shows the results of the flow analysis with the viscosity behavior before heating (blue line) and after heating (red line) under stress conditions (shear stress, Pa) and shear rate (s-1). We observed the coefficients obtained by regression of the power model, where “n” is the flow index and “K” is the consistency index. According to the consistency index, we see that “K” increases in all samples except for SIF-WM, because of the viscosity gain, being “n” and “K” inversely proportional parameters.

The graphs show the flow profile behavior of: (A) SIF-DM; (B) SIF-WM; (C) TF; (D) 25%SIF-DM:75%TF; (E) 25%SIF-WM:75%TF; (F) 50%SIF-DM:50%TF; (G) 50%SIF-WM:50%TF; (H) 75%SIF-DM:25%TF; (I) 75%SIF-WM:25%TF. The acronym (TF) refers to taro flour; (SIF-WM) sacha inchi flour by wet method and (SIF-DM) sacha inchi flour by defatted method.
Regarding the flowability index, we observed the behavior of the samples with the highest starch content TF were those that presented the greatest change in “n”, decreasing their flowability index represented by the gain in viscosity attributed to the behavior of the starch in taro.
Regarding the flow index, all the mixtures, except for SIF-DM, have a value of n > 1 before heating, showing that they have a dilettantish fluid behavior. In water and food starch suspensions, the dilatant or shear thickening behavior relates to the initial stiffness of starch granules to resist shear and to a high concentration of solids, resulting in particle swelling.52 SIF-DM presented an n of 0.7709, demonstrating a behavior of a pseudo-plastic fluid.
For the mixture’s behavior after heating, all the blends, except for SIF-WM, presented an n < 1, demonstrating a behavior of a pseudo-plastic fluid, i.e., that changes in temperature affect these mixtures behavior. This behavior occurs because, in the gelatinization process, the starch granules break, releasing amylose to the aqueous medium and, on cooling, these amylose chains align, forming networks that form gels or viscous suspensions.17 The n values for the SIF-WM were reduced to 1.064, exhibiting Newtonian behavior. The Newtonian flow shows that the viscosity is independent of the shear rate. According to Ref. 52, these flours could be suitable for formulating products such as beverages, where improving the nutritional content is required without affecting its viscosity during shearing.
Viscoelastic properties - Temperature sweeping
Figure 5 presents the moduli G′ (red color) and G″ (blue color) as a temperature function (°C). We observe the behavior of the elastic and viscous moduli for each mixture, evidencing an increase in the moduli as the temperature sweeps are performed. Except for graphs “A” and “H”, the mixtures behavior during heating is similar, since the two moduli increase their value, decreasing the difference between them and achieving a crosslinking, where the material ceases to have a viscous character, i.e., it stops being liquid and becomes elastic properties characteristic of a solid. This behavior is characteristic of materials undergoing liquid-solid phase transformations. When the molecules gain weight, in this case, when the starch granules interlock, the loss modulus G" decreases and the storage modulus G′ increases, reaching a point of equilibrium that is its material change of nature, its solidification.

The graphs show the loss modulus G" and storage modulus G' for: (A) SIF-DM; (B) SIF-WM; (C) TF; (D) 25%SIF-DM:75%TF; (E) 25%SIF-WM:75%TF; (F) 50%SIF-DM:50%TF; (G) 50%SIF-WM:50%TF; (H) 75%SIF-DM:25%TF; (I) 75%SIF-WM:25%TF. The acronym (TF) refers to taro flour; (SIF-WM) sacha inchi flour by wet method and (SIF-DM) sacha inchi flour by defatted method.
There is a progressive exudation of amylose in the swollen granules, where gel-like linkages are formed. Researchers have reported the effect of amylose to increase the firmness of gels during cooling as one of the initial causes of gel firmness. Thus, during the cooling stage, the moduli stay constant with the predominance of the elastic modulus.53
The behavior of flour blends A and H corresponding to 100% SIF-DM and 75% SIF-DM: 25% TF, respectively, shows that the G′ and G″ moduli remain constant both during the temperature increase and during subsequent cooling, thus presenting greater stability to temperature variations. This behavior responds to the low starch content of these samples, since starch is key for the viscoelastic behavior of the flours, due to the interaction with water, generating absorption and swelling of the granule and, consequently, greater viscoelasticity. SIF-DM and 75%SIF-DM:25%TF blends did not present a gel point, however, the other blends presented a gel-like behavior, highlighting that the 50%SIF-DM:50%TF and 25%SIF-DM:50%TF blends presented the most elastic gel at a gel temperature of 60 °C in both cases, showing similar viscoelastic characteristics.
We suggest an optimum level of protein inclusion represented by sacha inchi between 25 and 50%, where the consistency of the gel increases and mixtures prepared above this range do not present a gel point, while lower values will have a more liquid behavior.
Table 3 shows the results of the microbiological analysis performed on the three types of flour. For the microbiological analysis, we considered the NTC 606954 standard for quinoa flours and NTC 26755 for wheat flour.
As can be seen in Table 3, the flours comply with the quality specifications required by Colombian regulations; however, as shown in Figure 6, Salmonella is present in the taro flour, possibly due to the persistence of this type of microorganism; drying this flour at 60 °C preserves some bioactive compounds but is not sufficient to eliminate it. According to Ref. 14, this type of pathogens acquire resistance to disinfectants and temperature because they form biofilms, which protect them and can remain in equipment, utensils and facilities, contaminating food. In addition, flours such as taro can be contaminated during harvesting or transportation.
A: MKTTn broth, C: RVA broth, seeding of taro flour sample on Salmonella-Shigella agar B: MKTTn broth, D: RVA broth.
Table 2 shows that in foods such as sacha inchi and taro flour, where aw is less than 0.85, Salmonella and other pathogenic bacteria such as Staphylococcus can survive in a viable but non-culturable state for long periods of time due to their increased resistance to thermal processes.56 Although the growth of microorganisms is not maintained at low water activity, foodborne bacteria and fungi can easily contaminate flour and survive for long periods of time with a low reproduction rate.20
The method that allows for the highest concentration of protein in sacha inchi is mechanical defatting with a protein result of 73%, compared to that obtained by the wet method, which resulted in 31%. However, during the production of sacha flour with the mechanical method, bioactive compounds are lost, which is why lower values of total polyphenols and antioxidant activity are obtained, compared to taro flour.
The viscosity profile evaluation determined that the starch contained in taro provides good viscosity characteristics, being this an important ingredient for the development of foods such as creams, pastes, sauces, among others. However, mixtures with excess taro have a higher rate of retrogradation, presenting a disadvantage for food stability during storage.
Through the viscoelasticity analysis (temperature sweep), we found the optimum level of inclusion of defatted sacha inchi is between 25 and 50%, where a stable and consistent gel is presented.
Although taro’s drying temperature of 60 °C maintains polyphenols and antioxidant activity, it does not allow the inactivation of bacteria such as Salmonella, which has shown resistance to thermal treatment in recent years.
Developing foods using gluten-free orphan raw materials, especially taro and sacha inchi that are easily adapted to regions with food safety hazards, can be a good alternative to offer the market different gluten-free products, excellent source of protein, and high fiber content.
Future research can formulate foods from sacha inchi flour, which will allow obtaining high protein foods, responding to the trend of obtaining high protein foods from vegetable sources.
Salmonella contamination was present in the taro flour. In response, the facilities and equipment were washed and disinfected with a different product than usual, and again salmonella analyses were performed to guarantee its elimination.
Zenodo: Sacha_article, https://doi.org/10.5281/zenodo.7625871. 57
This project contains the following underlying data:
- REOLOGY SAMPLES.zip
• Flow profile analysis_folder containing data on the flow analysis of flours in different samples. (Folder contains data on flow analysis and statistical analysis of flours in different blends)
• Pasting_containing curves and statistical data of pasting properties in different samples. (Folder containing curves and statistical data of pasting properties)
• Viscoelasticity_containing curve data and statistical analysis of analyzed viscoelastic properties in different samples. (The folder contains the data of the curves and the statistical analysis of the viscoelastic properties analyzed)
Zenodo: Sacha_article, https://doi.org/10.5281/zenodo.7625871. 57
This project contains the following extended data:
Protocols on proximate and microbiological analysis
- Bacillus cereus--protocol for the determination of Bacillus cereus present in food according to the Colombian regulations is presented.docx. (This file contains the microbiology protocol for the determination of Bacillus cereus according to Colombian regulations)
- Coliforms--protocol for the determination of coliforms present in food according to the Colombian regulations is presented.docx. (This file contains the microbiology protocol for the determination of Coliforms according to Colombian regulations)
- Fungi and yeasts--protocol for the determination of fungi and yest present in food according to the Colombian regulations is presented.docx. (This file contains the microbiology protocol for the determination of Fungi and yeasts according to Colombian regulations)
- Mesophiles-- protocol for the determination of mesophiles present in food according to the colombian regulations is presented.docx. (This file contains the microbiology protocol for the determination of Mesophiles according to Colombian regulations)
- Salmonella Spp-- protocol for the determination of Samonella present in food according to the Colombian regulations is presented.docx. (This file contains the microbiology protocol for the determination of Salmonella Spp according to Colombian regulations)
- Staphylococcus aureus--protocol for the determination of Salmonella present in food according to the Colombian regulations is presented.docx. (This file contains the microbiology protocol for the determination of Staphylococcus aureus according to Colombian regulations)
- Protocol Fiber--protocol for fiber determination is presented.docx. (This file contains the proximal analysis protocol for fiber determination and handling of the equipment used for this determination)
- Protocol Lipid--protocol for lipds determination is presented.docx. (This file contains the proximal analysis protocol for lipds determination and handling of the equipment used for this determination)
- Protocol Protein--protocol for protein determination is presented.docx. (This file contains the proximal analysis protocol for protein determination and handling of the equipment used for this determination.)
Data are available under the terms of the Creative Commons Attribution 4.0 International license (CC-BY 4.0).
| Views | Downloads | |
|---|---|---|
| F1000Research | - | - |
|
PubMed Central
Data from PMC are received and updated monthly.
|
- | - |
Is the work clearly and accurately presented and does it cite the current literature?
Partly
Is the study design appropriate and is the work technically sound?
Yes
Are sufficient details of methods and analysis provided to allow replication by others?
Partly
If applicable, is the statistical analysis and its interpretation appropriate?
Yes
Are all the source data underlying the results available to ensure full reproducibility?
Yes
Are the conclusions drawn adequately supported by the results?
Yes
Competing Interests: No competing interests were disclosed.
Reviewer Expertise: Food science, food microbiology
Is the work clearly and accurately presented and does it cite the current literature?
Yes
Is the study design appropriate and is the work technically sound?
Partly
Are sufficient details of methods and analysis provided to allow replication by others?
Partly
If applicable, is the statistical analysis and its interpretation appropriate?
No
Are all the source data underlying the results available to ensure full reproducibility?
Yes
Are the conclusions drawn adequately supported by the results?
Yes
Competing Interests: No competing interests were disclosed.
Reviewer Expertise: Flour and Starch from Root and Tuber Crops as Alternatives to Wheat Flour
Is the work clearly and accurately presented and does it cite the current literature?
No
Is the study design appropriate and is the work technically sound?
Partly
Are sufficient details of methods and analysis provided to allow replication by others?
Partly
If applicable, is the statistical analysis and its interpretation appropriate?
No
Are all the source data underlying the results available to ensure full reproducibility?
No
Are the conclusions drawn adequately supported by the results?
Partly
Competing Interests: No competing interests were disclosed.
Reviewer Expertise: Food Science and Technology. Research in new sources of foods, andean crops, legumes, tubers.
Is the work clearly and accurately presented and does it cite the current literature?
No
Is the study design appropriate and is the work technically sound?
No
Are sufficient details of methods and analysis provided to allow replication by others?
Yes
If applicable, is the statistical analysis and its interpretation appropriate?
No
Are all the source data underlying the results available to ensure full reproducibility?
Yes
Are the conclusions drawn adequately supported by the results?
No
Competing Interests: No competing interests were disclosed.
Reviewer Expertise: Food Chemistry, Food processing and preservation, Encapsulation of bioactive compounds, Functional foods, Gamma irradiation.
Alongside their report, reviewers assign a status to the article:
| Invited Reviewers | |||||
|---|---|---|---|---|---|
| 1 | 2 | 3 | 4 | 5 | |
|
Version 4 (revision) 07 Mar 25 |
read | ||||
|
Version 3 (revision) 19 Nov 24 |
read | read | |||
|
Version 2 (revision) 09 Oct 23 |
read | read | |||
|
Version 1 06 Apr 23 |
read | read | |||
Provide sufficient details of any financial or non-financial competing interests to enable users to assess whether your comments might lead a reasonable person to question your impartiality. Consider the following examples, but note that this is not an exhaustive list:
Sign up for content alerts and receive a weekly or monthly email with all newly published articles
Already registered? Sign in
The email address should be the one you originally registered with F1000.
You registered with F1000 via Google, so we cannot reset your password.
To sign in, please click here.
If you still need help with your Google account password, please click here.
You registered with F1000 via Facebook, so we cannot reset your password.
To sign in, please click here.
If you still need help with your Facebook account password, please click here.
If your email address is registered with us, we will email you instructions to reset your password.
If you think you should have received this email but it has not arrived, please check your spam filters and/or contact for further assistance.
Comments on this article Comments (0)